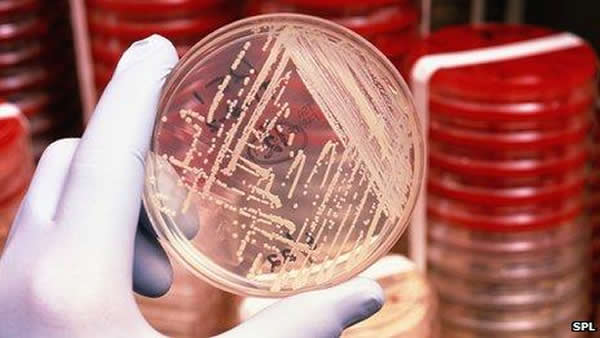
最新发现注射特定细菌能杀灭癌细胞

最新发现注射特定细菌能杀灭癌细胞
最新发现注射特定细菌能杀灭癌细胞
(蜘蛛网报道)据腾讯科学(清风):近日,在好莱坞举办的年度临床介入肿瘤学研讨会上,来自Anderson癌症研究中心的研究人员通过研究揭示了,利用细菌或许可以帮助治疗癌症。研究人员将一种名为诺维氏芽孢杆菌-NT(Clostridium novyi-NT)的细菌的孢子注射入6位病人机体的肿瘤中,随后细菌就可以在肿瘤中生长并且杀灭癌细胞。
诺维氏芽孢杆菌-NT生活在土壤中,其和引发食物中毒的芽孢杆菌非常相似,在将诺维氏芽孢杆菌-NT注射入癌症病人机体之前,研究人员首先通过移除该细菌的危险毒素来降低细菌的危险性;研究结果显示6位病人均存活下来了,但其中有一位病人在细菌注射后因一些非相关的原因发生了死亡。
研究者Ravi Murthy表示,当肿瘤生长达到一定尺寸后,其中一部分肿瘤组织就不再需要氧气了,其就会对常规的癌症疗法产生耐受性,比如对放疗和化疗产生耐受等;而诺维氏芽孢杆菌-NT则可以在无氧状态下生存从而在不影响正常组织的情况下破坏肿瘤细胞,同时该细菌也会诱发机体对癌症产生免疫反应。
从本质上来讲,诺维氏芽孢杆菌-NT在肿瘤组织中可以引发潜在的杀灭癌细胞的感染过程,本文研究对于后期开发新型的抗癌疗法提供了新的研究思路和依据。